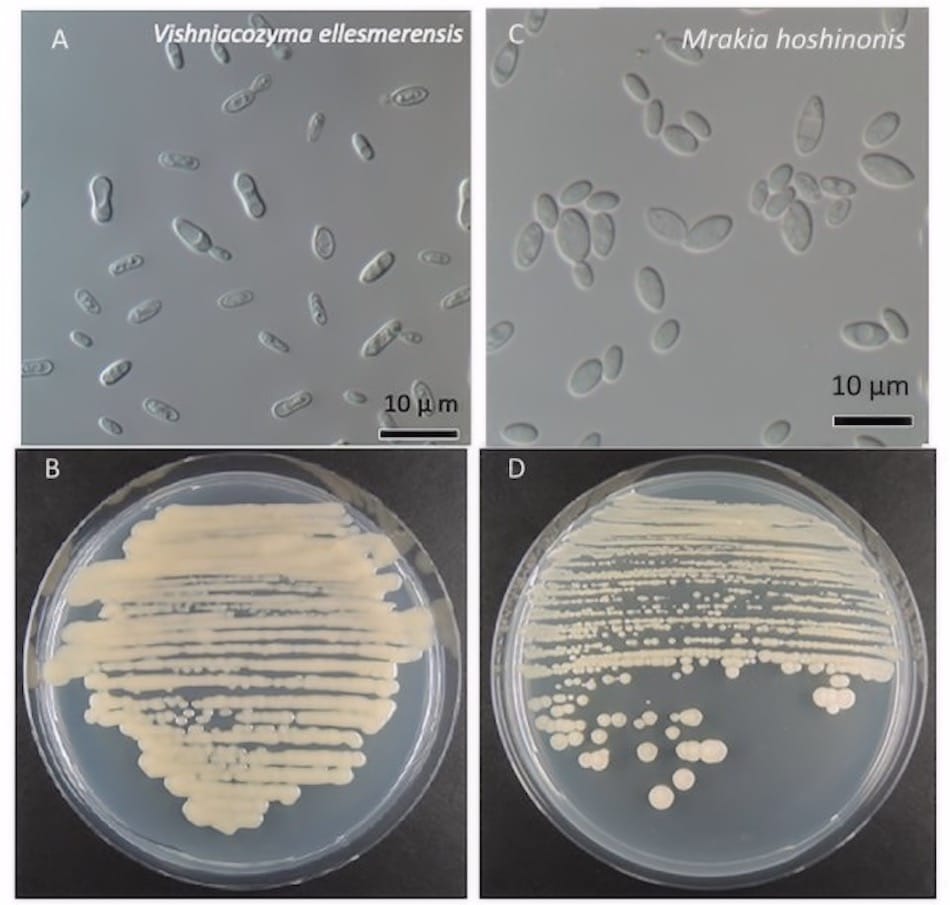
Die beiden neuentdeckten Pilzarten sind ähnlich wie Hefepilze und bilden bei guten Nährböden Kolonien. Links: Vishniacozyma ellesmerensis, rechts: Mrakia hoshinonis

Neue Pilzarten unter kanadischen Gletschern auf Ellesmere Island entdeckt
In der Arktis leben nicht nur die grossen Arten wie Eisbär, Walross oder Rentier. Viele der arktischen Bewohner sind klein und schwer zu entdecken. Dies gilt besonders für Arten, die an besonders schwer zugänglichen Lebensräumen vorkommen. Wegen des Klimawandels werden solche Habitate aber immer stärker exponiert. Dazu zählen vor allem Böden vor und unter Gletschern. Eine Forschergruppe aus Japan und Kanada hat nun zwei neue Pilzarten in Bodenproben von der Frontseite des Walker-Gletschers auf Ellesmere Island identifiziert. Dies zeigt, dass Leben auch unter enorm schwierigen Bedingungen gedeihen kann.

Ein Team aus Forscher des japanischen nationalen Instituts für Polarforschung (NIPR), der Universität für Angewandte Studien in Tokyo und der Laval Universität in Québec, Kanada, entdeckten zwei neue Pilzarten aus Bodenproben, die von einem sich schnell zurückziehenden Gletscher, bzw. dessen Front stammten. Die Ergebnisse der Arbeit wurden in zwei verschiedenen Fachzeitschriften, dem International Journal of Systematic und dem Evolutionary Microbiology veröffentlicht. „Die Kenntnisse über Pilze in der Arktis ist nur bruchstückhaft. Wir wollten bei unserer Arbeit eine Übersicht über die Artenvielfalt von Pilzen in der kanadischen Arktis erstellen“, erklärt Masahuru Tsuji, Wissenschaftler am NIPR und Hauptautor beider Veröffentlichungen. „Wir fanden tatsächlich zwei neue Pilzarten am gleichen Ort auf Ellesmere Island.“ Die beiden Arten gehören zu zwei verschiedenen Gattungen und sind jeweils die zehnte beziehungsweise die zwölfte Art innerhalb ihrer Gattungen. Beide erhielten einen speziellen Artnamen und sind Hefe-ähnliche Typen, die sehr gut an Kälte angepasst sind und auch bei Temperaturen unter 0° Celsius wachsen.
Die Proben wurden am nicht-offiziell benannten Walker-Gletscher auf Ellesmere Island entnommen. Messungen hatten gezeigt, dass der Gletscher sich zwischen 2009 und 2016 zweieinhalb Mal schneller zurückgezogen hatte, als die fünfzig Jahre zuvor. „Klima-relevante Effekte wurden in den letzten 20 Jahren in der Region häufig beobachtet“, sagt Tsuji. „Bald werden einige der Gletscher dort komplett verschwunden sein.“ Nur gerade fünf Prozent der vermuteten Pilzarten sind bisher beschrieben. Doch ihre Funktion in den verschiedenen Klimazonen ist klar: von den Tropen bis in die Arktis bauen Pilze totes organisches Material ab. Jede Art arbeitet dabei etwas anders, aber ihre generelle Rolle ist es, Nährstoffe aus abgestorbenem Material wieder in das System zurückzuführen. Wenn die Gletscher schmelzen, verlieren die arktischen Pilze aber ihren Lebensraum. Dadurch könnten katastrophale Folgeeffekte entstehen, gemäss Tsuji. Doch es werden weitere Studien noch notwendig sein, um genau zu verstehen, wie der Klimawandel die Pilze über reine Zerstörung hinaus beeinflusst. Dazu möchten die Wissenschaftler die Pilze im Ward Hunt-See, dem nördlichsten See der Welt, untersuchen. Der See liegt auf der Insel Ward Hunt, die an der nördlichen Küste von Ellesmere Island liegt und nur noch rund 800 Kilometer vom Nordpol entfernt ist. „Normalerweise schmilzt das Eis auch im Sommer nicht. Doch 2016 war das Eis komplett verschwunden. Wir planen, kontinuierlich die Veränderungen der Pilzarten im See zu untersuchen“, sagt Tsuji. Die verschiedenen Arten könnten sich anpassen oder aussterben. „Zum Schluss würden wir alle unsere Studien zusammenlegen und eine Übersicht über die terrestrischen Ökosysteme in der Arktis und der Antarktis erstellen.“

Quelle: Research Organization of Information and System